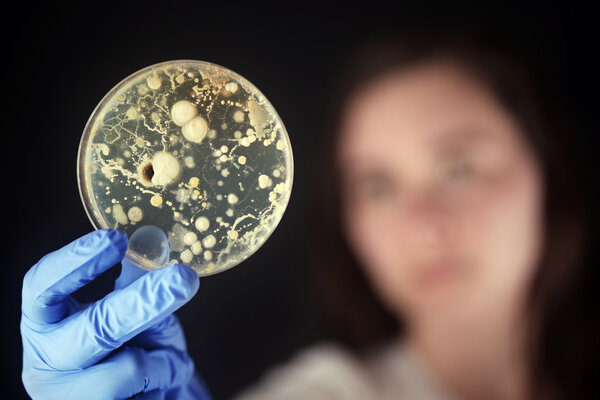
Examining bacteria in a petri dish
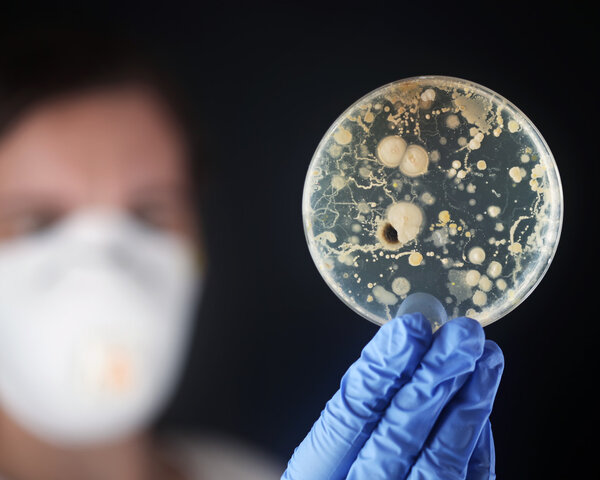
Examining bacteria in a petri dish
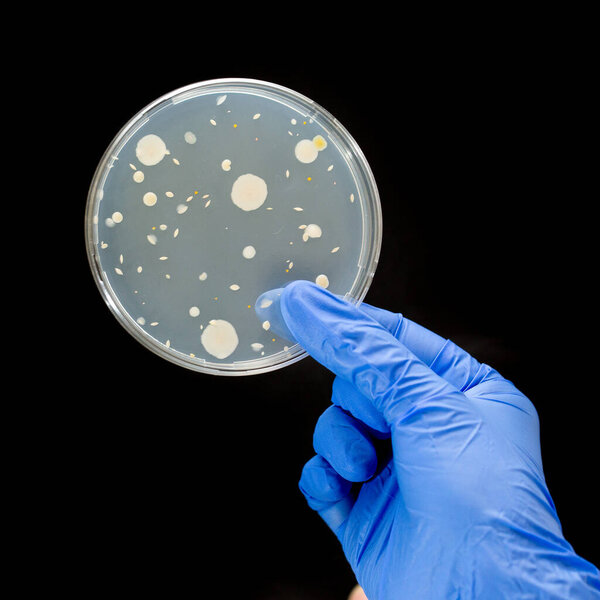
Hand with blue gloves holding bacterial culture
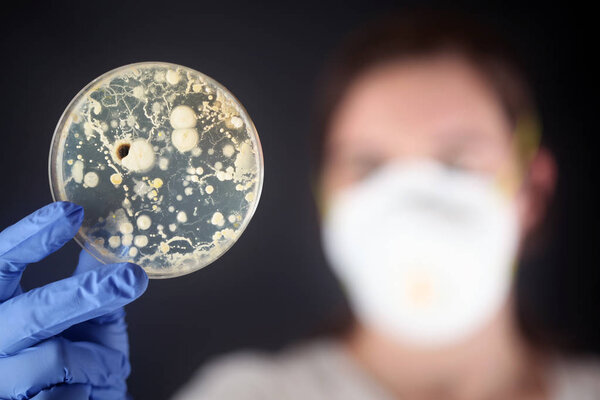
Examining bacteria in a petri dish
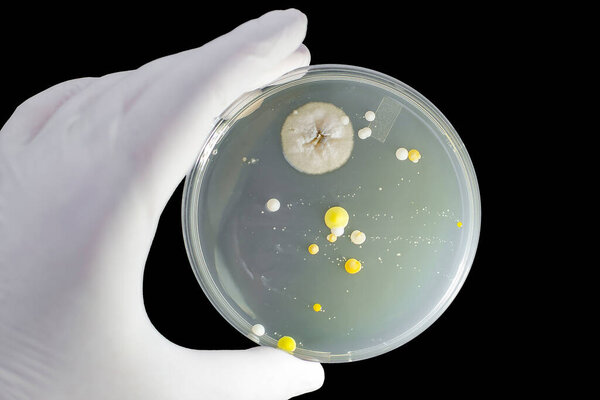
Colonies of different bacteria and mold fungi grown on Petri dish with nutrient agar, close-up view, isolated on black background

- /
- Search /
- Examining bacteria in a petri dish
Examining bacteria in a petri dish
Examining bacteria in a petri dish
image
image
Aug.11, 2016 11:16:17
21.03
0.67
333x500
667x1000
1333x2000
3744x5616
3744x5616
318
45
SSilver